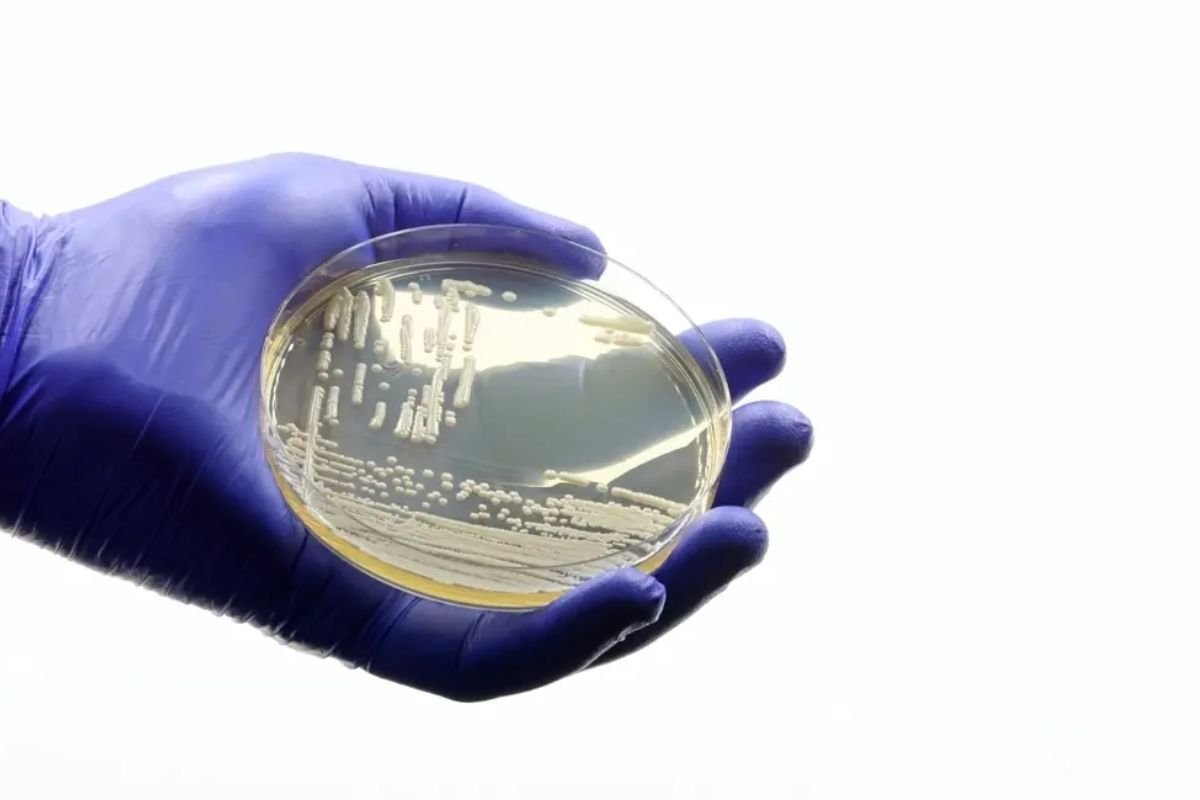
Sesap confirma caso do fungo Candida auris em paciente internado no Hospital Walfredo Gurgel, em Natal. Homem está isolado e em monitoramento.

A Secretaria de Estado da Saúde Pública (Sesap) confirmou a identificação de um caso do fungo Candida auris em um paciente internado no Hospital Central Coronel Pedro Germano, em Natal. A confirmação ocorreu após a realização de dois exames no Laboratório Central do Estado (Lacen). O homem permanece em isolamento, em tratamento por outra enfermidade, e não apresenta, até o momento, agravamento relacionado à infecção pelo fungo.
Leia também:
Conselho Federal de Enfermagem autoriza prescrição de antibióticos por enfermeiros no Brasil
Monitoramento e medidas de contenção
De acordo com a Sesap, as equipes do hospital estão adotando protocolos rigorosos de controle de infecção para evitar a contaminação de outros pacientes e de profissionais de saúde.
As equipes de vigilância em saúde também realizam o monitoramento e o rastreio do caso, com acompanhamento contínuo da unidade hospitalar.
Segundo a secretaria, a transmissão do fungo ocorre apenas por contato direto, não apresentando alto nível de contaminação aérea ou ambiental.
O que é o Candida auris
Conhecido como “superfungo”, o Candida auris tem gerado preocupação em escala mundial por causa da sua alta resistência aos medicamentos antifúngicos e da facilidade de disseminação em ambientes hospitalares.
No Brasil, o primeiro registro da infecção ocorreu em Salvador, em 2020, durante o período mais crítico da pandemia de Covid-19.
Na época, a superlotação das Unidades de Terapia Intensiva (UTIs) e a dificuldade dos serviços de saúde em manter integralmente os protocolos de controle de infecções contribuíram para o surgimento e a disseminação do fungo.
Risco maior em ambientes hospitalares
Especialistas alertam que o Candida auris representa maior risco para pacientes internados em estado grave, especialmente aqueles que utilizam cateteres, respiradores ou apresentam imunidade comprometida.
A Sesap reforçou que segue acompanhando o caso e adotando todas as medidas preventivas necessárias para evitar a propagação do fungo na rede hospitalar do estado.